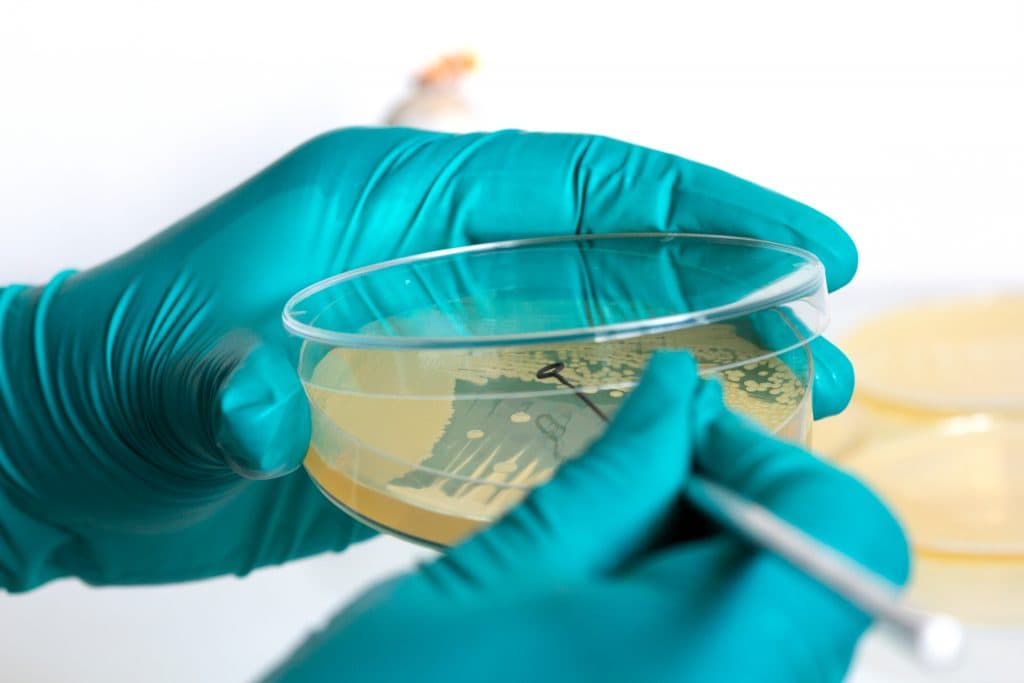
CellularREvolution

As countries across the world slowly exit their respective lockdowns, attention still remains on how life can go back to normal while minimising the transmission of COVID-19.
Although they have proved effective, social distancing methods can not be viewed as a long-term indefinite strategy for this.
Thankfully there are a number of companies and academics developing technologies that are looking to put an end to the pandemic sooner rather than later.
youvee air purifier – Frenell
Letting fresh air in allowing COVID-19 particles to blow out has been one of the key strategies used to help stop the spread of the virus.
This is not always possible in every room, so German solar company Frenell has developed youvee which uses UVC technology to disinfect air particles..
The device is able to kill 99.99 per cent of viruses, including SARS-CoV-2, by breaking down its DNA/RNA in a fraction of a second, with the developers saying it can clean around 800 cubic meters of air per hour.
Traditionally hardware like this has been exclusive to clinical settings such as hospitals or operating theatres.
However, the events of the last year have seen a rise in consumer demand for such technology, with the firm now offering this to businesses for use in offices, restaurants and classrooms.
At-home testing kit – Ellume and Cambridge Consultants
Keeping track of those who have contracted COVID-19 is vital to limiting transmission and the technology surrounding this has drastically improved since the start of the pandemic.
Patients previously had to wait up to 24 hours to get their results back, but now they can receive them in as little as 15 minutes thanks to a Ellume and Cambridge Consultants collaboration.
The test is 96 per cent accurate and quicker results will help speed up the decision making when it comes to a patient’s isolation, allowing for a safer and more efficient track and trace system.
What stands out about the Ellume and Cambridge Consultants test is it can be done from home.
This further prevents the spread of coronavirus as patients can use it without coming into contact with others.
CliniTouch Vie – Spirit Digital
This practice of isolation has been commonplace in the last year, with statistics showing that 25 per cent of the British population were completely removing themselves from others in March 2020.
This has furthered the acceleration of remote healthcare options, none more so that Spirit Digital’s CliniTouch Vie system which has been used to care for symptomatic COVID-19 patients after their hospital discharge.
The platform allows its users to regularly answer specific questions related to coronavirus and take vital signs readings, including oxygen saturation levels.
From this data the software is able to produce a risk rating – either green, amber or red – which is sent directly to their clinician.
From this potential signs of further deterioration can be assessed, with a hospital recall available alongside further at home care options.
The Fake News Immunity Chatbot – Universities of Liverpool and Dundee
Misinformation surrounding COVID-19 has been rife since the start of the pandemic and has only amplified since the vaccine rollout began.
The University of Liverpool and the University of Dundee have developed a tool to end this in the form of The Fake News Immunity Chatbot.
The software is a game-like service that challenges its users to identify the fake and semi-fake news surrounding the virus.
It brings three classic philosophers to life on screen in the form of Aristotle, Socrates and Gorgia who all have separate functions around the importance of accurate information.
With three different levels, the game presents news items and users are asked to determine what is true about them and why, with the education system encouraging people to be more resilient to misinformation.
Mobile Medical Carts – Ergotron
COVID vaccination centres are popping up all over the UK and Ergotron are allowing almost any location to become one with their Mobile Medical Carts.
The technology allows for the seamless running of the equipment needed to carry out the vaccination process as well as providing remote access to medical records.
Ergotron have also installed thermal imaging hardware on these carts to detect any high temperature of a patient who is receiving the jab – one of the key symptoms of coronavirus.
The stations primarily allow for extended runtime of computer based IT technology, charging up to 30 laptops at once up to 40 per cent faster.
So far it has allowed areas such as car parks and football stadiums to be turned into on-demand vaccine facilities.
Vaccination Passport – myGP
Although it is a controversial subject it looks increasingly likely that vaccination passports will play a role in the UK returning to normality, especially in the short-term.
This has been boosted by the UK’s first approved system of this kind when myGP launched the software last month.
Currently around 97 per cent of GP practices in the country use the medical record system, with the company adding the new TICKet feature which shows if a person has had their vaccination.
Initially trialled in two care homes, this option is expected to be used to accelerate the reopening of the hospitality sector, with Harlequins Rugby Club already agreeing to test it at one of their home fixtures.
Once a patient has had their second booster shot and has waited 12 days for optimal immunity their profile will be covered with a green tick which allows events staff to easily identify who is safe to enter their venue.